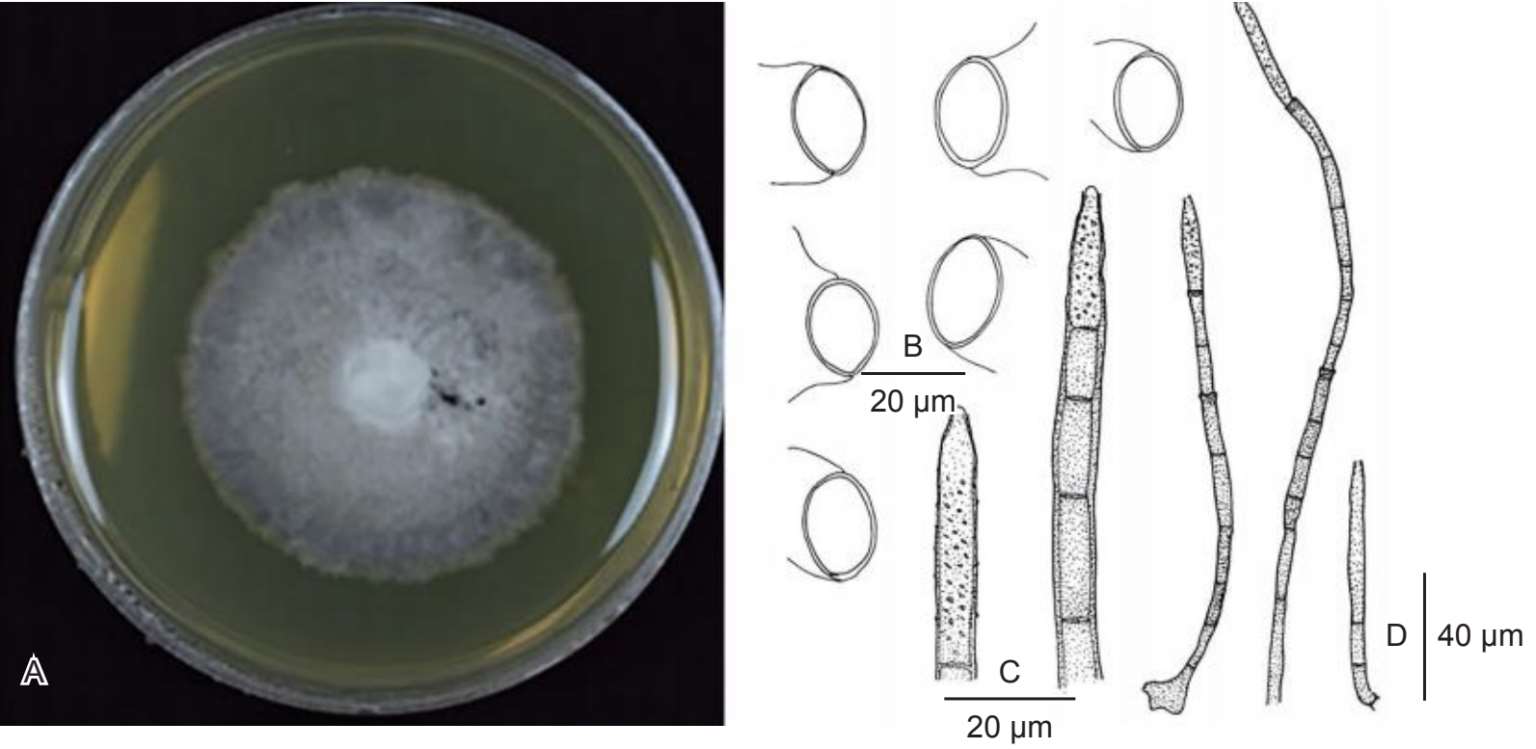

形态特征 │菌落外延,有毛,深棕色。菌丝薄,部分侵入基质,浅棕色至棕色,分枝,有隔。有性型未知。无性型:分生孢子梗200~300微米×4.5~5.5微米,巨线状,单生,直立,直或稍弯曲,圆柱形,深棕色,7~12个隔,光滑,壁厚,穿过囊领在顶部增殖。产分生孢子细胞23~30微米×4~5微米,完整,顶生,圆柱形,浅棕色至棕色,疣状,顶端具一个狭窄的产孢座,没有囊领或有一小囊领。分生孢子15~17微米×11.5~12.5微米,全裂,顶生,单生,近球形,椭圆体,无隔,透明,光滑,每端有一个刚毛状囊状体插入,长8~10微米。培养特征:马铃薯葡萄糖琼脂培养基上菌落外延,20天内直径1.5~2.5厘米,圆形,平整,边缘全缘。气生菌丝发育不良,灰色至灰棕色,边缘淡色,反面同色或稍深。
生境 │阔叶树枯枝上。
模式标本 │标本号HMAS 351966(=Wu1900a);吴文平1998年10月9日采于鼎湖山;保存于中国科学院微生物研究所菌物标本馆(HMAS)。
A.马铃薯葡萄糖琼脂培养基上培养的中华鞋形小孢菌菌落;B.分生孢子;C.分生孢子梗和产分生孢子细胞;D.分生孢子梗
图片来源:Wu Wenping,et al.,2022.Fungal diversity,116:79,102